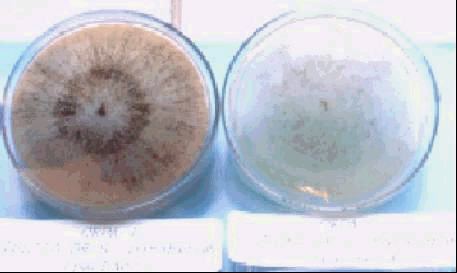

0294-B3
Carlos Belezaca Pinargote 1 y Carmita Suárez Capello 2
El Schizolobium parahybum (Pachaco) es una especie forestal introducida al Ecuador. A medida que fueron desarrollándose rodales puros se manifestaron problemas fitopatológicos diversos, destacándose una pudrición del fuste acompañada de marchitamiento vascular de carácter letal y etiología compleja. En la Estación Experimental Tropical Pichilingue (EETP) del Instituto Nacional Autónomo de Investigaciones Agropecuarias del Ecuador (INIAP) se realizó esta investigación para definir el cuadro sintomatológico asociado a la misma y determinar su etiología. Al evaluarse la incidencia de la enfermedad, la zona de la Provincia de Los Ríos con de más 25 años de edad presento el 54,76 % de árboles muertos; la zona de la Provincia de Esmeraldas con 29,52 % y 8 años de edad; la Provincia de Pichincha, en una plantación de 4 años con 23,78 %. La enfermedad es de avance lento, inicialmente presenta clorosis foliar, muerte y desprendimiento de los brotes. En ramas y fuste se presentan manchas marrón oscuro en la corteza. En estados avanzados, la decoloración del fuste se torna gris rojizo, compromete el xilema y produce exudación de color amarillo y olor característico. Ceratocystis paradoxa, C. moniliformis, Graphium sp. (anamorfo de Ophiostoma quersi), Macrophoma sp., Fusarium sp. se encontraron asociados a la enfermedad. El primero se presentó en las plantaciones más vieja y la mas joven; C. moniliformis solo se aisló de la plantación joven, mientras que Graphium sp, Macrophoma sp y Fusarium sp. se aislaron de todas las muestras. En las pruebas de patogenicidad realizadas en plántulas de seis meses, el avance de la enfermedad se midió en función del volumen de necrosis. C. paradoxa, y C. moniliformis presentaron los mayores volúmenes, con 3,67 y 2,88 cm³, 90 días después de la inoculación. Los otros tres organismos produjeron una lesión similar a la causada por el corte sin inocular en el testigo.
La creciente demanda de madera por los mercados Nacionales e Internacionales ha provocado la búsqueda de especies forestales de rápido crecimiento y buena calidad de madera (Masson 1995). Las especies no siempre son nativas de una región sino que son introducidas de otras. Para obtener mejores rendimientos las especie se encuentran establecidas en plantaciones puras, para cuyo efecto se han eliminado áreas donde existían especies nativas (Betancourt 1987).
Estas son condiciones ideales para la aparición de problemas fitosanitarios provocados por patógenos nativos de la zona que reaccionan de forma agresiva al no tener las condiciones del ecosistema original. Adicionalmente el mal manejo de las plantaciones, raleos con herramientas inadecuadas, rompimiento de ramas de árboles vecinos provocan que las plantas estén predispuestas al ataque de patógenos causantes de pudriciones basales (Stakman y Harrar 1968)
Este es el caso del S. parahybum (pachaco) introducido de Costa Rica en la década de 1950 a las áreas tropicales del Ecuador. Actualmente esta especie forestal presenta una extraña enfermedad asociada con una compleja sintomatología que mata los árboles en pie. Inversiones hechas por los madereros se encuentran amenazadas por la enfermedad y también la estabilidad de la especie en el trópico Ecuatoriano.
Con la finalidad de conocer los agentes patógenos asociados a la muerte del pachaco se estableció la investigación con los siguientes objetivos: 1) Identificar el o los organismos patógenos causantes de la muerte del pachaco. 2) Desarrollar información sobre la descripción de síntomas asociados a la muerte del pachaco.
La investigación se la realizó en tres zonas experimentales, tomando en cuenta provincias diferentes, a continuación se detalla la ubicación geográfica; Zona 1) 79° 24' 14'' de longitud Occidental y 01° 04' 26'' de latitud sur, Prov. de Los Ríos; Zona 2) 79° 22' de longitud Occidental y 0° 01' de latitud sur, Prov. del Pichincha; Zona 3) 79° 13' de longitud Occidental y 0° 18' de latitud sur, Prov. de Esmeraldas.
Las observaciones y experimentos de patogenicidad se realizaron en el laboratorio e invernaderos del Departamento Nacional de Protección Vegetal (DNPV) de la estación Experimental Tropical Pichilingue del Instituto Nacional Autónomo de Investigaciones Agropecuarias (INIAP), ubicada a 5 Km. de la vía Quevedo, El Empalme, siendo sus coordenadas geográficas 79° 24' 14'' de longitud Occidental y 01° 04' 26'' de latitud sur1/
En el cuadro número 1 se detallan las principales características agroclimáticas correspondientes a las zonas de estudio.
Cuadro N° 1. Promedios de variables agroclimáticas registrados en las tres zonas de investigación.
Variables |
Prov. Los Ríos |
Prov. Pichincha |
Prov. Esmeraldas |
Localización |
Prov. de Los Ríos. |
Prov. de Pichincha |
Prov. Esmeraldas. |
Precipitación |
2905,2 mm. |
3851,7 mm. |
4059 mm. |
Temperatura |
24,68 °C. |
24,13 °C. |
25,31 °C. |
Humedad Relativa |
86,53 %. |
87,35 %. |
87,52 %. |
Heliofanía |
915 horas luz año. |
842 horas luz año. |
898 horas luz año. |
Altitud |
120 msnm. |
250 msnm. |
200 msnm. |
La plantación de pachaco de la zona 1 tiene más de 25 años. La de la zona 2 una edad de 4 años. Y la zona 3 con 8 años de edad. En cada zona experimental se realizaron observaciones de síntomas de la enfermedad, para lo cual se anotaron las diferencias morfológicas del fuste, ramas y hojas y se compararon con árboles sanos.
En las 3 zonas experimentales se evaluó la incidencia de la enfermedad en porcentaje (% I) de acuerdo a la siguiente fórmula.
N° de árboles enfermos
IE % =----------------------------------------- x 100
N° Total de árboles
En cada área experimental se colectaron muestras del 5 % del total de árboles existentes. El medio de cultivo utilizado en la investigación fue PDA (Papa, Dextrosa, Agar más tiamina HCl al 0.005 %,2/ preparado fresco. Una vez obtenidos cultivos puros de los organismos asociados a la enfermedad se procedió a su identificación con la ayuda de claves micológicas. Para la identificación a nivel de especies, se enviaron cultivos tipo al Department of Plant Pathology de IOWA State University (EE.UU.)
Los tratamientos utilizados en las pruebas de patogenicidad estuvieron conformados por los microorganismos aislados. Se utilizó un Diseño Completamente al Azar (DCA) con 6 tratamientos y 20 unidades de observación, los datos se analizaron bajo el esquema de análisis de varianza que se indica en el cuadro 2. La separación de medias entre tratamientos se lo hizo mediante la prueba de rangos múltiples de Tukey a nivel de 0,05 de probabilidad.
Cuadro N° 2. Esquema del análisis de varianza utilizado en las pruebas de patogenicidad con 20 unidades de observación.
|
Fuente de Variación |
Grados de Libertad |
Total t . r (-1) 6 . 20 ( - 1) |
119 |
Tratamientos t - 1 (6 - 1) |
5 |
Error t (r . 1) 6 (20 - 1) |
114 |
Con un bisturí estéril se realizó un corte oblicuo en el fuste de las plantas de pachaco a aproximadamente 10 cm. sobre el nivel del suelo, previa limpieza y desinfección del área a cortar con alcohol al 75%. Dentro de la herida se coloco 1 cm³ de la suspensión de esporas del organismo que correspondiera a cada tratamiento. Se utilizo concentraciones de 250000 esporas/ml de cada uno, calibrada con cámara de Newbawer, seguidamente se cubrió la herida con algodón hidrófilo húmedo estéril y parafilm. Se evaluó a los 90 días.
La enfermedad que ocasiona la muerte de los árboles de pachaco se presenta en forma descendente, las hojas pierden su coloración verde oscuro y se tornan cloróticas, las yemas terminales de las ramas empiezan a secarse ocasionando la posterior muerte de las ramas, las mismas que se caen o quedan suspendidas hacia abajo, la corteza de las ramas toman un color marrón oscuro. En el fuste se presenta una pudrición circular que en un principio torna al xilema de una coloración café claro a gris rojizo, de donde emana constantemente un líquido de color amarillo claro a café oscuro con un fuerte olor a materia en descomposición. En los árboles fuertemente atacados por la enfermedad, la pudrición alcanza algunos centímetros de profundidad, lo que ocasiona la destrucción del tejido vascular del área circular del fuste tornando al xilema de color café oscuro a pardo oscuro, provocando finalmente la muerte del árbol (Fig. 1 A y B).
Cuando la muerte descendente empieza en árboles jóvenes, estos tratan de defenderse emitiendo brotes epicórmicos, a medida que la enfermedad avanza estos se secan y quedan adheridos al fuste. Los árboles continúan emitiendo brotes epicórmicos hasta que la enfermedad extermina completamente al árbol.
1A
1B
Fig. 1 A y B. Sintomatología con que se manifiesta la enfermedad en los árboles de S. parahybum. 1A = heridas con fluidos en descomposición; 1B = Muerte de los árboles en pie (regresiva).
La incidencia de la enfermedad fue más alta en la zona 1 (54,76 %), mientras que en la zona 2 y 3 alcanzaron 23,78 y 29,52 % respectivamente, como se observa en la figura 2.

De los árboles evaluados se aislaron los siguientes géneros de hongos : Ceratocystis, Graphium, Macrophoma, y Fusarium. Del género Ceratocystis se aislaron dos especies muy diferentes (Fig. 3 y 4), siendo identificadas posteriormente por el Dr. Thomas Harrington (Department of Plant Pathology. IOWA State University) como C. paradoxa y C. moniliformis.
C. paradoxa C. moniliformis
Figura N° 3. Diferencia morfológicas entre C. paradoxa y C. moniliformis a las 96 horas en medio de cultivo Papa, Dextrosa, Agar.

C. paradoxa C. moniliformis
Figura N° 4. Aspecto de los peritecios de C. paradoxa y C. moniliformis obtenidos en S. parahybum..
En el cuadro número 3 se encuentra detallada la frecuencia de aparición de los microorganismos, el número de árboles en los que aparecieron tanto en cámara húmeda y medio de cultivo por cada zona de estudio.
Cuadro 3. Frecuencia de presencia de microorganismos en las tres zonas de estudio.
EDAD EN AÑOS | ||||||
> 25 |
4 |
8 | ||||
Microorganismos |
Zona 1 |
Zona 2 |
Zona 3 | |||
M. C.1/ |
C. H.2/ |
M. C.1/ |
C. H.2/ |
M. C.1/ |
C. H.2/ | |
Ceratocystis paradoxa |
0 |
5 |
0 |
0 |
0 |
3 |
Ceratocystis moniliformis |
0 |
5 |
0 |
0 |
0 |
0 |
Graphium sp. |
0 |
3 |
0 |
3 |
0 |
3 |
Macrophoma sp. |
5 |
4 |
18 |
15 |
10 |
4 |
Fusarium sp. |
4 |
3 |
12 |
5 |
6 |
0 |
| Donde: 1/ = Medio de Cultivo; 2/ = Cámara húmeda. |
C. paradoxa se encontró en todos los árboles de la muestra en la zona 1 y en tres árboles de la zona 3, mientras que en la zona 2 no se encontró este patógeno. C. moniliformis solo se encontró en los árboles de la zona 1. Graphium sp. se presentó en tres árboles de las tres zonas experimentales. C. paradoxa, C. moniliformis y Graphium sp. solo se manifestaron en cámara húmeda, ya que en medio de cultivo crecían rápidamente especies del género Fusarium que probablemente impidieron que éstos se manifiesten.
Macrophoma sp. apareció consistentemente tanto en cámara húmeda como en medio de cultivo mostrando la importancia que tiene en el desarrollo de la enfermedad que ocasiona la muerte de los árboles de pachaco. Nótese la consistencia con la que aparece Macrophoma sp. en todos los árboles muestreados de las tres zonas experimentales.
C. paradoxa presentó mayor volumen aparente de necrosis, 3,67 cm³, existiendo diferencias altamente significativas en relación con los demás tratamientos C. moniliformis, Macrophoma sp., Fusarium sp., Graphium sp y Testigo (agua destilada estéril).
C. moniliformis mostró 2,88 cm³ de volumen aparente de necrosis, presentando diferencias estadísticas altamente significativas con respecto a los demás tratamientos. Pese a que Macrophoma sp. no fue el hongo que ocasionó mayor volumen de necrosis (1,68 cm³) en las plantas inoculadas, si mostró el mayor rango de infección haciendo notar su peligrosidad en plantaciones genéticamente susceptibles (Cuadro 4).
Cuadro N° 4. Valores de Volumen aparente de necrosis alcanzados por los microorganismos en estudio transformados a v(x+1)
Microorganismos |
Media de volumen aparente de necrosis en cm³. |
v(X+1) |
Ceratocystis paradoxa |
3,67 |
2,14 a |
Ceratocystis moniliformis |
2,88 |
1,86 b |
Macrophoma sp. |
1,68 |
1,62 c |
Testigo. |
1,32 |
1,52 c |
Fusarium sp. |
1,34 |
1,51 c |
Graphium sp. |
1,05 |
1,42 c |
|
CV. 11.48 % | ||
Promedios con la misma letra no difieren estadísticamente según Tukey al 5 % de probabilidad.
La enfermedad de la pudrición del fuste de S. parahybum (pachaco), presentó sintomatología similar en los tres sitios experimentales. La incidencia de la enfermedad varió en cada zona (sitio). En la Estación Experimental Tropical Pichilingue (zona 1) se observo una incidencia del 55 %, valor superior al 19,10 % encontrado por Ramírez 1990. Este incremento en la incidencia de la enfermedad posiblemente se debe a la edad de la plantación, ya que sobrepasa los 20 años de edad, y como todo organismo vivo a edades mas avanzadas, mayor susceptibilidad a enfermarse. Además existieron árboles caídos que con sus ramas han lesionado las raíces tablares, fuste y ramas de los árboles vecinos, brindando la puerta de entrada a patógenos de los géneros Ceratocystis, Macrophoma, y Fusarium que colonizan rápidamente las heridas.
En las plantaciones de las zonas 2 y 3 la enfermedad tuvo una incidencia menor, siendo de 24 y 29 %, respectivamente.
De acuerdo a estas pruebas, C. paradoxa aparenta ser el agente causal primario de la muerte de pachaco seguido de C. moniliformis. Sin embargo al no encontrarlos en todas las tres zonas experimentales, hay que considerar que aparentemente hay mas de un agente causal de los síntomas observados. Tal es el caso de Macrophoma sp. aunque no fue el microorganismo que alcanzó mayor patogenicidad si fue aquel que estuvo presente en todas las muestras en las 3 zonas experimentales haciendo notar su peligrosidad. Esto concuerda con lo expresado por Holliday 1980, quien menciona que Macrophoma es conocido por su capacidad de causar daño en especies leñosas. Botryosphaeria spp. representa su estado sexual (Hanlin 1992).
La incidencia de la enfermedad de la pudrición del fuste de S. parahybum (pachaco) fue mayor en la zona de la Estación Experimental Tropical Pichilingue (Prov. Los Ríos) donde los árboles eran más viejos y tenían poco o ningún manejo.
C. paradoxa fue el hongo que presentó mayor patogenicidad con un promedio de volumen aparente de necrosis de 3,67 cm³.
3. C. moniliformis y Macrophoma sp. y también mostraron un poder patogénico alto, por lo que se concluye que la muerte regresiva de S. parahybum es consecuencia del ataque de Ceratocystis spp. y Macrophoma sp. solos o combinados.
Aunque en las pruebas de patogenicidad Macrophoma sp. no fue el hongo que presentó el mayor volumen de necrosis, se lo encontró asociado a todos los árboles en las tres zonas experimentales y podría ser un agente causal principal de la muerte de S. parahybum en el Litoral Ecuatoriano.
La patogenicidad de C. paradoxa, C. moniliformis, y Macrophoma sp. en S. parahybum (pachaco) es el primer reporte para Ecuador. C. paradoxa antes no ha sido reportado atacando especies forestales y ha sido usualmente patogénico en monocotiledóneas.
En esta investigación no se encontró C. fimbriata asociada a S. parahybum.
Betancourt, A. 1987. Silvicultura especial de árboles Maderables Tropicales. Ed. Científica Técnica. La Habana, Cuba. Pp. 241 - 249.
Hanlin R. 1992. Illustrated genera of Ascomycetes. APS. PRESS. The American Phytopathological Society. St. Paul, Minnesota. Pp 18 - 20 ; 48 - 49.
Hollyday P. 1980. Fungus diseases of tropical crops. Cambridge University Press. Gran Bretaña. Pp 253 -254.
Masson, J. 1995. Revista Gestión. N° 7. Pp 22 - 23.
Poehlman J. 1987. La genética y su relación con el fitomejoramiento. In Mejoramiento de las cosechas. Universidad de Missouri. Ed. Ciencia y Técnica, S.A. México. Pp 41 - 45 (Volumen 1).
Stakman, E. 1969. Principios de patología vegetal. Buenos Aires, Argentina. Ed. Universitaria. Pp 256 - 258.
1 Ing. Forestal. Asistente de Investigación. Estación Experimental Tropical Pichilingue. Departamento Nacional de Protección Vegetal (DNPV) del Instituto Nacional Autónomo de Investigaciones Agropecuarias del Ecuador (INIAP). E:mail: [email protected]
2 Ph D. Fitopatólogo. Líder del Departamento Nacional de Protección Vegetal (DNPV) ) del Instituto Nacional Autónomo de Investigaciones Agropecuarias del Ecuador (INIAP).
E:mail: suá[email protected]
3 Coordenadas registradas con GPS MAGELLAN 315.
4 Commonwealth Mycological Institute. 1968. Plant Pathologist's Pocketbook. London.